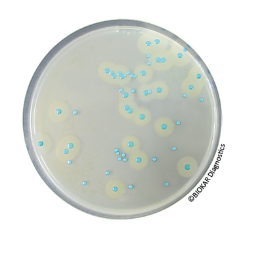
COMPASS® Listeria Agar

3/4″ Amplifier plus filter with auto drain model 90004
$0.00
3/4″ Amplifier plus filter with auto drain model 90004
MANUFACTURER: NEXFLOW
PRODUCT CODE: AM10-1
- Description
- Size Guide
- Vendor Info
- More Products
Description
PRODUCT OVERVIEW
The Fixed Standard Air Amplifier from Nex Flow™ is die cast for rugged use. The gap can be adjusted by adding shims, five sizes are available. It is easy to mount and maintain reducing both compressed air consumption and noise levels. It is quiet, and can amplify flows up to 16 times their input air consumption rate
APPLICATIONS
- Vent welding smoke
- Cool hot parts
- Dry wet parts
- Clean machined parts
- Distribute heat in molds/ovens
- Ventilate confined areas
- Dust collection
- Exhaust tank fumes
ADVANTAGES
- Compact, lightweight, portable
- No electricity
- No moving parts – no maintenace
- Ends are easily ducted
- Instant on/off